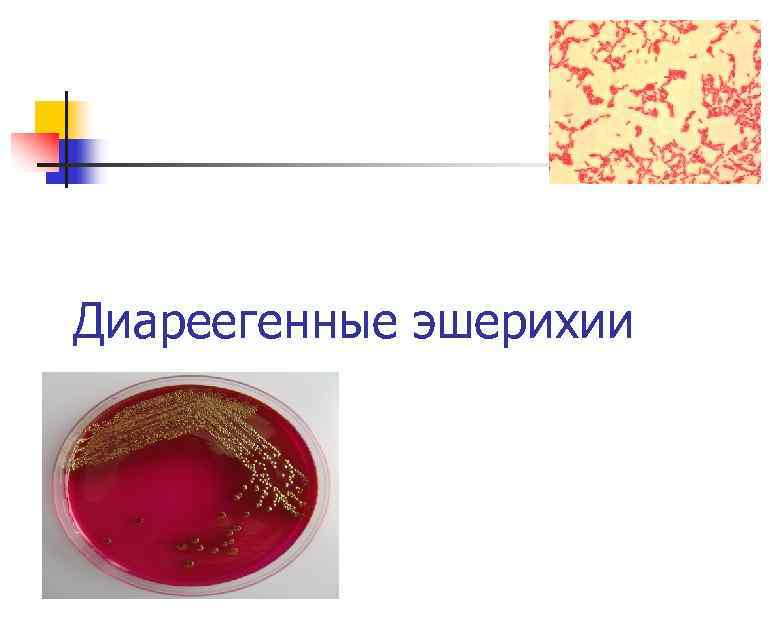
Диареегенные эшерихии
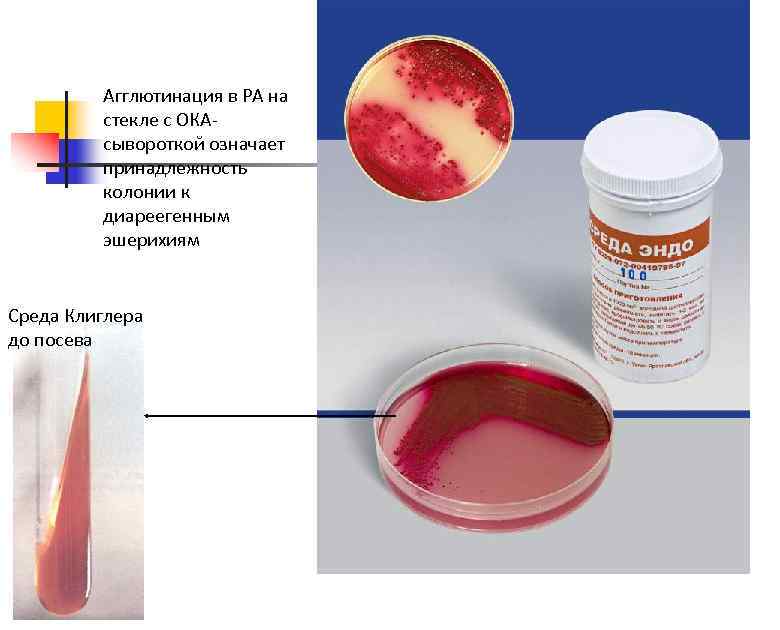
Агглютинация в РА на стекле с ОКАсывороткой означает принадлежность колонии к диареегенным эшерихиям Среда

coli.ppt
- Количество слайдов: 35
Диареегенные эшерихии
Диареегенные эшерихии
 q В настоящее время известно около 170 антигенных вариантов Е. coli; более 80 из них вызывают колиинфекцию. q Диареегенные эшерихии отличаются от остальных эшерихий, в том числе от банальной кишечной палочки – комменсала ЖКТ , антигенными свойствами, факторами патогенности, особенностями патогенеза, локализацией патологического процесса, клинически и эпидемиологически.
q В настоящее время известно около 170 антигенных вариантов Е. coli; более 80 из них вызывают колиинфекцию. q Диареегенные эшерихии отличаются от остальных эшерихий, в том числе от банальной кишечной палочки – комменсала ЖКТ , антигенными свойствами, факторами патогенности, особенностями патогенеза, локализацией патологического процесса, клинически и эпидемиологически.
 Возбудители кишечных коли-инфекций: Ø Энтеропатогенные E. coli (ЭПКП); Ø Энтеротоксигенные E. coli (ЭТКП); Ø энтероинвазивные E. coli (ЭИКП); Ø Энтерогеморрагические E. coli (ЭГКП); Ø Энтероаггрегирующие E. coli (ЭАКП) Ø Диффузно-адгерентные E coli (DAEC) Возбудители внекишечных эшерихиозов: Ø Уропатогенные E. coli Ø Септицемические E. coli Ø Менингит-ассоциированные E. coli
Возбудители кишечных коли-инфекций: Ø Энтеропатогенные E. coli (ЭПКП); Ø Энтеротоксигенные E. coli (ЭТКП); Ø энтероинвазивные E. coli (ЭИКП); Ø Энтерогеморрагические E. coli (ЭГКП); Ø Энтероаггрегирующие E. coli (ЭАКП) Ø Диффузно-адгерентные E coli (DAEC) Возбудители внекишечных эшерихиозов: Ø Уропатогенные E. coli Ø Септицемические E. coli Ø Менингит-ассоциированные E. coli

 q Морфология. Прямые грамотрицательные палочки размером 0, 4 -0, 6 x 2 -6 мкм, подвижные за счет перитрихиально расположенных жгутиков, могут иметь микрокапсулу q Факультативные анаэробы q Культуральные свойства. Не требовательны к питательным средам, на плотных средах образуют гладкие полупрозрачные колонии. На дифференциальных средах (Эндо, Левина) образуют окрашенные колонии (лактозопозитивные) q Биохимические свойства: обладают выраженной биохимической активностью
q Морфология. Прямые грамотрицательные палочки размером 0, 4 -0, 6 x 2 -6 мкм, подвижные за счет перитрихиально расположенных жгутиков, могут иметь микрокапсулу q Факультативные анаэробы q Культуральные свойства. Не требовательны к питательным средам, на плотных средах образуют гладкие полупрозрачные колонии. На дифференциальных средах (Эндо, Левина) образуют окрашенные колонии (лактозопозитивные) q Биохимические свойства: обладают выраженной биохимической активностью
 Дифференциация эшерихий n n n Подвижность Ферментацию глюкозы с газообразованием Ферментация лактозы Образование индола Отсутствие образования сероводорода «Неактивные» E. coli имеют сниженную биохимическую активность
Дифференциация эшерихий n n n Подвижность Ферментацию глюкозы с газообразованием Ферментация лактозы Образование индола Отсутствие образования сероводорода «Неактивные» E. coli имеют сниженную биохимическую активность
 Антигены n n n О-антиген – ЛПС наружной мембраны клеточной стенки, полисахаридная часть; термостабильный; по О-антигену разделяют на серогруппы Н-антиген – жгутиковый белок флагеллин, термолабильный, отвечает за деление на серотипы К-антиген – поверхностные полисахариды, термолабильны, как правило, мешают определению О-антигенной специфичности (Оинагглютинабельность). По отношению к температуре подразделяют на L и В-антигены – термолабильные и А-антиген – термостабильный По О-антигену или сочетанию О и К-антигенов эшерихии разделены на серогруппы По сочетанию О: К: Н или О: Н – на серовары Антигенная формула: О 55: К 59: Н 6 или О 157: Н 7
Антигены n n n О-антиген – ЛПС наружной мембраны клеточной стенки, полисахаридная часть; термостабильный; по О-антигену разделяют на серогруппы Н-антиген – жгутиковый белок флагеллин, термолабильный, отвечает за деление на серотипы К-антиген – поверхностные полисахариды, термолабильны, как правило, мешают определению О-антигенной специфичности (Оинагглютинабельность). По отношению к температуре подразделяют на L и В-антигены – термолабильные и А-антиген – термостабильный По О-антигену или сочетанию О и К-антигенов эшерихии разделены на серогруппы По сочетанию О: К: Н или О: Н – на серовары Антигенная формула: О 55: К 59: Н 6 или О 157: Н 7



 Энтеротоксигенные E. coli (ETEC, ЭТЭ, ЭТКП) § ЭТКП являются возбудителями холероподобного заболевания у детей и взрослых, известного под названием «диарея путешественников» . § Патогенность связана с выработкой 2 энтеротоксинов, которые вызывают развитие секреторной диареи: термолабильного (LT), структурно и функционально связанного с холерным токсином, и термостабильного (ST) энтеротоксинов. Синтез обоих токсинов детерминируется плазмидой. § Факторами патогенности также являются пили IV типа, которые называются факторами колонизации CF (от англ. colonization factors). Их синтез контролируется второй плазмидой. Факторы колонизации CF являются пилями IV типа. § Благодаря CF ЭТКП прикрепляются и размножаются на поверхности эпителия тонкой кишки. § Колонизация поверхности тонкой кишки обеспечивает массивный выброс энтеротоксинов, которые нарушают водно -солевой обмен в кишечнике, приводя к развитию водянистой диареи. § Механизм развития диареи связывают с активацией аденилатциклазы LT кишечника, а гуанилатциклазы - ST.
Энтеротоксигенные E. coli (ETEC, ЭТЭ, ЭТКП) § ЭТКП являются возбудителями холероподобного заболевания у детей и взрослых, известного под названием «диарея путешественников» . § Патогенность связана с выработкой 2 энтеротоксинов, которые вызывают развитие секреторной диареи: термолабильного (LT), структурно и функционально связанного с холерным токсином, и термостабильного (ST) энтеротоксинов. Синтез обоих токсинов детерминируется плазмидой. § Факторами патогенности также являются пили IV типа, которые называются факторами колонизации CF (от англ. colonization factors). Их синтез контролируется второй плазмидой. Факторы колонизации CF являются пилями IV типа. § Благодаря CF ЭТКП прикрепляются и размножаются на поверхности эпителия тонкой кишки. § Колонизация поверхности тонкой кишки обеспечивает массивный выброс энтеротоксинов, которые нарушают водно -солевой обмен в кишечнике, приводя к развитию водянистой диареи. § Механизм развития диареи связывают с активацией аденилатциклазы LT кишечника, а гуанилатциклазы - ST.
 Энтеропатогенные E. coli (EPEC, ЭПЭ, ЭПКП) § ЭПКП вызывают диарею у детей первого года жизни. § Заболевание может также протекать как внутрибольничная инфекция в отделениях для новорожденных и грудных детей, находящихся на искусственном вскармливании. § Заболевание передается контактно-бытовом путем. § Пили и белок-интимин обеспечивают тесное взаимодействие бактериальной клетки с эпителиоцитом, а в результате действия эффекторных белков секреторной системы в месте прикрепления бактериальной клетки к эпителиоциту формируется пьедестал, который является результатом реорганизации клеточного цитоскелета эффекторными белками, представляя собой полимеризованный актин. § Процесс размножения на поверхности эпителия тонкой кишки, приводящий к разрушению микроворсинки и повреждению апикальной поверхности эпителия, известен под названием «прикрепление и сглаживание» § В результате в участке прикрепления бактерий к эпителию тонкой кишки происходит дегенерация эпителиальной поверхности, сопровождающаяся потерей эпителиальных микроворсинок и сборкой пьедесталоподобной актиновой структуры, следствием чего является уменьшение всасывающей поверхности кишечника. § Некоторые серовары, например О 55: Н 10, O 111 H 2, O 26 HNM, продуцируют шигаподобные токсины.
Энтеропатогенные E. coli (EPEC, ЭПЭ, ЭПКП) § ЭПКП вызывают диарею у детей первого года жизни. § Заболевание может также протекать как внутрибольничная инфекция в отделениях для новорожденных и грудных детей, находящихся на искусственном вскармливании. § Заболевание передается контактно-бытовом путем. § Пили и белок-интимин обеспечивают тесное взаимодействие бактериальной клетки с эпителиоцитом, а в результате действия эффекторных белков секреторной системы в месте прикрепления бактериальной клетки к эпителиоциту формируется пьедестал, который является результатом реорганизации клеточного цитоскелета эффекторными белками, представляя собой полимеризованный актин. § Процесс размножения на поверхности эпителия тонкой кишки, приводящий к разрушению микроворсинки и повреждению апикальной поверхности эпителия, известен под названием «прикрепление и сглаживание» § В результате в участке прикрепления бактерий к эпителию тонкой кишки происходит дегенерация эпителиальной поверхности, сопровождающаяся потерей эпителиальных микроворсинок и сборкой пьедесталоподобной актиновой структуры, следствием чего является уменьшение всасывающей поверхности кишечника. § Некоторые серовары, например О 55: Н 10, O 111 H 2, O 26 HNM, продуцируют шигаподобные токсины.
 A. Электронная микрофотография клеток слизистой кишечника кролика, инфицированная энтеропатогенной кроличьей Escherichia coli (EPEC) B. B. Взаимодействие EPEC со слизистой кишечника. Ø Начальная адгезия с помощью пилий, которая также опосредует аггрегацию бактерий. Ø Далее инициальное прикрепление, и EPEC секретирует в клетку хозяина некоторые факторы вирулентности (секреция IIIтипа). Ø В клетке начинается активация фосфолипазы С и протеинкиназы, Ca 2+ высвобождается из внутренних хранилищ. Ø Бактерия более тесно прикрепляется к клетке, продуцирует в клетку хозяина свой собственный рецептор и дополнительно закрепляется за его наружную часть. Ø Актин, миозин и некоторые другие белки цитоскелета подходят к месту адгезии. Ø Реорганизованный цитоскелет образует фундамент для проживания бактерии на поверхности клетки.
A. Электронная микрофотография клеток слизистой кишечника кролика, инфицированная энтеропатогенной кроличьей Escherichia coli (EPEC) B. B. Взаимодействие EPEC со слизистой кишечника. Ø Начальная адгезия с помощью пилий, которая также опосредует аггрегацию бактерий. Ø Далее инициальное прикрепление, и EPEC секретирует в клетку хозяина некоторые факторы вирулентности (секреция IIIтипа). Ø В клетке начинается активация фосфолипазы С и протеинкиназы, Ca 2+ высвобождается из внутренних хранилищ. Ø Бактерия более тесно прикрепляется к клетке, продуцирует в клетку хозяина свой собственный рецептор и дополнительно закрепляется за его наружную часть. Ø Актин, миозин и некоторые другие белки цитоскелета подходят к месту адгезии. Ø Реорганизованный цитоскелет образует фундамент для проживания бактерии на поверхности клетки.
 Патогенез поражений определяется адгезией возбудителей к эпителию тонкого кишечника, повреждением микроворсинок, однако без инвазии в клетку. Вирулентность этих бактерий связана с наличием особого генного локуса, который находится в составе хромосомного островка патогенности – локуса «стирания энтероцитов» . Данный локус кодирует различные факторы патогенности. Важнейшие из них – адгезин интимин и рецепторный для него белок Tir. Для направленной доставки рецепторного Tir-белка в энтероциты у возбудителей имеется специализированная органелла инжектисома (или иглокомплекс). В ее состав входят сократительные белки. Инжектисома относится к системе III типа секреции бактерий, которая обеспечивает активное поступление белков патогенности в пораженные клетки.
Патогенез поражений определяется адгезией возбудителей к эпителию тонкого кишечника, повреждением микроворсинок, однако без инвазии в клетку. Вирулентность этих бактерий связана с наличием особого генного локуса, который находится в составе хромосомного островка патогенности – локуса «стирания энтероцитов» . Данный локус кодирует различные факторы патогенности. Важнейшие из них – адгезин интимин и рецепторный для него белок Tir. Для направленной доставки рецепторного Tir-белка в энтероциты у возбудителей имеется специализированная органелла инжектисома (или иглокомплекс). В ее состав входят сократительные белки. Инжектисома относится к системе III типа секреции бактерий, которая обеспечивает активное поступление белков патогенности в пораженные клетки.
 В норме на энтероцитах Tir-рецептора нет. Однако он присутствует в бактериальной клетке. После контакта E. сoli с клетками эпителия тонкой кишки с помощью инжектисомы происходит впрыскивание белков, составляющих Tir-рецептор к интимину, внутрь эпителиоцита. Через некоторое время этот рецептор появляется на мембране энтероцита. E. сoli посредством интимина присоединяется к внедренному Tirрецептору. Это обеспечивает прочную адгезию микроба с поверхностью эпителиальных клеток. Кроме того, Tir-рецептор активирует перестройку внутриклеточного актина и других белков в месте прикрепления микробов. В результате после присоединения большого количества бактерий происходит сглаживание и стирание микроворсинок эпителия кишечника. При этом может развиваться локальное воспаление. Все это ведет к нарушению всасывания, расстройству электролитного обмена и диарее.
В норме на энтероцитах Tir-рецептора нет. Однако он присутствует в бактериальной клетке. После контакта E. сoli с клетками эпителия тонкой кишки с помощью инжектисомы происходит впрыскивание белков, составляющих Tir-рецептор к интимину, внутрь эпителиоцита. Через некоторое время этот рецептор появляется на мембране энтероцита. E. сoli посредством интимина присоединяется к внедренному Tirрецептору. Это обеспечивает прочную адгезию микроба с поверхностью эпителиальных клеток. Кроме того, Tir-рецептор активирует перестройку внутриклеточного актина и других белков в месте прикрепления микробов. В результате после присоединения большого количества бактерий происходит сглаживание и стирание микроворсинок эпителия кишечника. При этом может развиваться локальное воспаление. Все это ведет к нарушению всасывания, расстройству электролитного обмена и диарее.
 (D)Сканирующая электронная микрофотография энтеропатогенных Е. coli, прикрепляющихся к опороподобным клеточным выростам на поверхности He. La клеток. (E) Окружение Shigella flexneri цитоплазматическими выростами клеток (по типу ряби), во время вторжения бактерий в He. La эпителиальные клетки.
(D)Сканирующая электронная микрофотография энтеропатогенных Е. coli, прикрепляющихся к опороподобным клеточным выростам на поверхности He. La клеток. (E) Окружение Shigella flexneri цитоплазматическими выростами клеток (по типу ряби), во время вторжения бактерий в He. La эпителиальные клетки.
 Энтероинвазивные E. coli (EIEC, ЭИЭ, ЭИКП) ЭИКП вызывают дизентериеподобные заболевания у взрослых и детей. n Патологический процесс локализуется в толстой кишке и нижнем отделе подвздошной n От шигелл приобрели плазмиду, кодирующую синтез поверхностных эффекторных ТТСС белков: n IPA-антигенов, опосредующих процесс инвазии в клетки слизистой оболочки толстой кишки, n и белок Vir. G, обеспечивающий сборку актина. Результатом действия этих факторов патогенности является размножение в эпителиальных клетках слизистой оболочки толстой кишки с последующей их деструкцией ЭИКП приобрели и некоторые антигены шигелл, что обеспечивает их агглютинацию шигеллезными сыворотками Подобно шигеллам они неподвижны, не ферментируют лактозу, не образуют газ при ферментации глюкозы Вирулентность ниже, чем у шигелл, поэтому заболевание протекает по типу пищевой токсикоинфекции после критического накопления возбудителя в пищевом продукте Заражение ЭИКП происходит водным и элементарными путями, возможны вспышки внутрибольничных инфекций, вызванных ЭИКП. n § § §
Энтероинвазивные E. coli (EIEC, ЭИЭ, ЭИКП) ЭИКП вызывают дизентериеподобные заболевания у взрослых и детей. n Патологический процесс локализуется в толстой кишке и нижнем отделе подвздошной n От шигелл приобрели плазмиду, кодирующую синтез поверхностных эффекторных ТТСС белков: n IPA-антигенов, опосредующих процесс инвазии в клетки слизистой оболочки толстой кишки, n и белок Vir. G, обеспечивающий сборку актина. Результатом действия этих факторов патогенности является размножение в эпителиальных клетках слизистой оболочки толстой кишки с последующей их деструкцией ЭИКП приобрели и некоторые антигены шигелл, что обеспечивает их агглютинацию шигеллезными сыворотками Подобно шигеллам они неподвижны, не ферментируют лактозу, не образуют газ при ферментации глюкозы Вирулентность ниже, чем у шигелл, поэтому заболевание протекает по типу пищевой токсикоинфекции после критического накопления возбудителя в пищевом продукте Заражение ЭИКП происходит водным и элементарными путями, возможны вспышки внутрибольничных инфекций, вызванных ЭИКП. n § § §
 Энтерогеморрагические E. coli (ЭГКП, EHEC) n n Острые кишечные инфекции с проявлениями геморрагического колита (ГК) и гемолитикоуремического синдрома (HUS), вызываемые эшерихиями, продуцирующими шигатоксины (STEC), распространены во многих странах мира и регистрируются в виде спорадических случаев или вспышек с охватом больших количеств людей: от десятков до нескольких тысяч. Заражение происходит при употребления недоброкачественных мясных продуктов, непастеризованного молока, йогуртов, сыра, овощей, шпината, разных салатов, пророщенных зерен бобовых, соков, других пищевых продуктов и воды, обсемененных STEC-бактериями. Возможно заражение людей при контакте с сельскохозяйственными и домашними животными, а также при непосредственном контакте с больными STEC-инфекцией. Штаммы EHEC представляют серьезную угрозу жизни особенно для пожилых людей и детей до 5 лет. Источником и основным резервуаром этого патогена являются сельскохозяйственные животные: крупный рогатый скот, овцы, козы, свиньи и птица, а также дикие животные.
Энтерогеморрагические E. coli (ЭГКП, EHEC) n n Острые кишечные инфекции с проявлениями геморрагического колита (ГК) и гемолитикоуремического синдрома (HUS), вызываемые эшерихиями, продуцирующими шигатоксины (STEC), распространены во многих странах мира и регистрируются в виде спорадических случаев или вспышек с охватом больших количеств людей: от десятков до нескольких тысяч. Заражение происходит при употребления недоброкачественных мясных продуктов, непастеризованного молока, йогуртов, сыра, овощей, шпината, разных салатов, пророщенных зерен бобовых, соков, других пищевых продуктов и воды, обсемененных STEC-бактериями. Возможно заражение людей при контакте с сельскохозяйственными и домашними животными, а также при непосредственном контакте с больными STEC-инфекцией. Штаммы EHEC представляют серьезную угрозу жизни особенно для пожилых людей и детей до 5 лет. Источником и основным резервуаром этого патогена являются сельскохозяйственные животные: крупный рогатый скот, овцы, козы, свиньи и птица, а также дикие животные.
 Энтерогеморрагические E. coli (ЭГКП, EHEC) n n Факторы патогенности: шигаподобные токсины SLT-I, SLT-II, адгезин интимин и эффекторные белки ТТСС; сериновая протеаза и гемолизин Развитие ГК и HUS обусловлено действием шигаподобных токсинов, которые блокируют синтез белка в эндотелии мелких кровеносных сосудов, в том числе почек, что ведет к кровотечению, ишемии и некрозу тканей. Сериновая протеаза нарушает процесс свертывания крови.
Энтерогеморрагические E. coli (ЭГКП, EHEC) n n Факторы патогенности: шигаподобные токсины SLT-I, SLT-II, адгезин интимин и эффекторные белки ТТСС; сериновая протеаза и гемолизин Развитие ГК и HUS обусловлено действием шигаподобных токсинов, которые блокируют синтез белка в эндотелии мелких кровеносных сосудов, в том числе почек, что ведет к кровотечению, ишемии и некрозу тканей. Сериновая протеаза нарушает процесс свертывания крови.

 Схема выделения и идентификации E. coli O 157: H 7/O 157: H-
Схема выделения и идентификации E. coli O 157: H 7/O 157: H-
 Энтероаггрегиррующие E. coli (ЭАКП, EAgg. EC) n n n ЭАКП являются преобладающим этиологическим агентом персистирующей диареи в развивающихся странах и медленно текущей диареи в индустриально развитых странах. Особенность возбудителя заключается в том, что они прикрепляются к эпителиальным клеткам в характерной манере, напоминающей укладку кирпичей. Прикрепляясь к слизистой оболочке кишечника, они стимулируют продукцию слизи, приводя к образованию толстой слизистой биопленки, инкрустированной ЭАГКП. Образование биопленки усиливает персистенцию микроба и создает барьер, препятствующий проникновению антибиотиков и антибактериальных факторов хозяина. В развитии заболевания участвуют: фимбриальные адгезины (AAF), синтез которых опосредуется плазмидой 65 МД, высокоиммуногенный белок дисперзин, который, связываясь с клеточной поверхностью, принимает участие в образовании биопленки, а также термостабильный энтеротоксин-1 и токсины с цитотоксическим эффектом. § Неинвазивны § Обнаружены только у человека. § Не все представители групп EAg. EC способны вызывать ОКИ у человека, как правило, болеют лица с ослабленной сопротивляемостью к инфекциям (дети раннего возраста, лица пожилого возраста, ВИЧ-инфицированные и др. ).
Энтероаггрегиррующие E. coli (ЭАКП, EAgg. EC) n n n ЭАКП являются преобладающим этиологическим агентом персистирующей диареи в развивающихся странах и медленно текущей диареи в индустриально развитых странах. Особенность возбудителя заключается в том, что они прикрепляются к эпителиальным клеткам в характерной манере, напоминающей укладку кирпичей. Прикрепляясь к слизистой оболочке кишечника, они стимулируют продукцию слизи, приводя к образованию толстой слизистой биопленки, инкрустированной ЭАГКП. Образование биопленки усиливает персистенцию микроба и создает барьер, препятствующий проникновению антибиотиков и антибактериальных факторов хозяина. В развитии заболевания участвуют: фимбриальные адгезины (AAF), синтез которых опосредуется плазмидой 65 МД, высокоиммуногенный белок дисперзин, который, связываясь с клеточной поверхностью, принимает участие в образовании биопленки, а также термостабильный энтеротоксин-1 и токсины с цитотоксическим эффектом. § Неинвазивны § Обнаружены только у человека. § Не все представители групп EAg. EC способны вызывать ОКИ у человека, как правило, болеют лица с ослабленной сопротивляемостью к инфекциям (дети раннего возраста, лица пожилого возраста, ВИЧ-инфицированные и др. ).
 Диффузно-адгерентные E coli (DAEC) n n n n Характеризуются образованием диффузных аггрегатов на эпителиальных клетках He. La или HEp-2 Обладают адгезинами семейства Afa/Dr После связывания адгезинами происходит «демонтаж» актина в энтероцитах, приводящий к удлинения микроворсинок и перераспределению белков цитоскелета Последнее обеспечивают ТТСС белки-эффекторы (см. секреция III типа) Обнаружены автотранспортеры – сериновые протеазы, способные повреждать связи эпителиальных клеток с повышением проницаемости DAEC демонстрируют провоспалительные эффекты. Связанные с повышенной секрецией интерлейкина- 8 эпителиальными клетками. Штаммы DAEC , несущие гены вирулентности, обнаружены в составе нормальной микрофлоры клинически здоровых детей.
Диффузно-адгерентные E coli (DAEC) n n n n Характеризуются образованием диффузных аггрегатов на эпителиальных клетках He. La или HEp-2 Обладают адгезинами семейства Afa/Dr После связывания адгезинами происходит «демонтаж» актина в энтероцитах, приводящий к удлинения микроворсинок и перераспределению белков цитоскелета Последнее обеспечивают ТТСС белки-эффекторы (см. секреция III типа) Обнаружены автотранспортеры – сериновые протеазы, способные повреждать связи эпителиальных клеток с повышением проницаемости DAEC демонстрируют провоспалительные эффекты. Связанные с повышенной секрецией интерлейкина- 8 эпителиальными клетками. Штаммы DAEC , несущие гены вирулентности, обнаружены в составе нормальной микрофлоры клинически здоровых детей.

 E. coli O 104: H 4 n n Серовар E. coli O 104: H 4 , явившийся причиной крупной эпидемической вспышки геморрагического колита и тяжелых случаев HUS в Германии и других странах Европы весной-летом 2011 года, охватившей более 4000 человек, по своим культуральным, биохимическим и другим фенотипическим свойствам является типичным представителем вида Е. coli. Генотип этого высоковирулентного для человека штамма вобрал в себя факторы патогенности энтероаггрегативных эшерихий (способность к аггрегации и образованию биопленки на слизистой кишечника) и энтерогеморрагических (способность к синтезу веротоксина (шигаподобного токсина) Stx 2 - основного фактора, обусловливающего HUS у человека). Кроме того, эпидемический штамм E. coli O 104: H 4 характеризуется широким спектром устойчивости к антибактериальным препаратам: к бета-лактамам - ампициллину, амоксициллину/клавулонату, пиперациллину/сульбактаму, пиперациллину/тазобактаму, цефуроксину, цефуроксиму, цефокситину, цефотаксиму, цефтазидиму, цефподоксиму, а также к стрептомицину, налидиксовой кислоте, тетрациклину и триметоприму/сульфаметоксазолу. Устойчивость к бета-лактамам обусловлена присутствием в геноме штамма бета-лактамаз расширенного спектра (БЛРС) - СТХ-М-15 и ТЕМ-1.
E. coli O 104: H 4 n n Серовар E. coli O 104: H 4 , явившийся причиной крупной эпидемической вспышки геморрагического колита и тяжелых случаев HUS в Германии и других странах Европы весной-летом 2011 года, охватившей более 4000 человек, по своим культуральным, биохимическим и другим фенотипическим свойствам является типичным представителем вида Е. coli. Генотип этого высоковирулентного для человека штамма вобрал в себя факторы патогенности энтероаггрегативных эшерихий (способность к аггрегации и образованию биопленки на слизистой кишечника) и энтерогеморрагических (способность к синтезу веротоксина (шигаподобного токсина) Stx 2 - основного фактора, обусловливающего HUS у человека). Кроме того, эпидемический штамм E. coli O 104: H 4 характеризуется широким спектром устойчивости к антибактериальным препаратам: к бета-лактамам - ампициллину, амоксициллину/клавулонату, пиперациллину/сульбактаму, пиперациллину/тазобактаму, цефуроксину, цефуроксиму, цефокситину, цефотаксиму, цефтазидиму, цефподоксиму, а также к стрептомицину, налидиксовой кислоте, тетрациклину и триметоприму/сульфаметоксазолу. Устойчивость к бета-лактамам обусловлена присутствием в геноме штамма бета-лактамаз расширенного спектра (БЛРС) - СТХ-М-15 и ТЕМ-1.
 Клиническая классификация эшерихиозов принятая в России(Ющук Н. Д. , Венгеров Ю. Я. , 1999) По этиологическим признакам: n энтеротоксигенные; n энтероинвазивные; n энтеропатогенные; n энтерогеморрагические; n энтероадгезивные. По тяжести течения: § лёгкое; § средней тяжести; § тяжёлое. По форме заболевания: n гастроэнтеритическая; n энтероколитическая; n гастроэнтероколитическая; n генерализованная (колисепсис, менингит, пиелонефрит, холецистит).
Клиническая классификация эшерихиозов принятая в России(Ющук Н. Д. , Венгеров Ю. Я. , 1999) По этиологическим признакам: n энтеротоксигенные; n энтероинвазивные; n энтеропатогенные; n энтерогеморрагические; n энтероадгезивные. По тяжести течения: § лёгкое; § средней тяжести; § тяжёлое. По форме заболевания: n гастроэнтеритическая; n энтероколитическая; n гастроэнтероколитическая; n генерализованная (колисепсис, менингит, пиелонефрит, холецистит).
 Иммунитет q При кишечных эшерихиозах вырабатывается местный иммунитет, опосредованный секреторными Ig. A. q После кишечного эшерихиоза, вызванного ЭТКП, происходит выработка антител к субъединице В LT, иммунологически родственной субъединице В холерного энтеротоксина. q У детей первого года жизни пассивный трансплацентарный иммунитет к ЭПКП обеспечивается проходящими через плаценту Ig. G. q Естественный иммунитет детей первого года жизни обеспечивают бифидобактерии, которые колонизируют кишечник к 5 -му дню жизни, и антитела, находящиеся в материнском молоке. q Надежный иммунитет к возбудителям парентеральных эшерихиозов не вырабатывается. Специфическая профилактика не разработана.
Иммунитет q При кишечных эшерихиозах вырабатывается местный иммунитет, опосредованный секреторными Ig. A. q После кишечного эшерихиоза, вызванного ЭТКП, происходит выработка антител к субъединице В LT, иммунологически родственной субъединице В холерного энтеротоксина. q У детей первого года жизни пассивный трансплацентарный иммунитет к ЭПКП обеспечивается проходящими через плаценту Ig. G. q Естественный иммунитет детей первого года жизни обеспечивают бифидобактерии, которые колонизируют кишечник к 5 -му дню жизни, и антитела, находящиеся в материнском молоке. q Надежный иммунитет к возбудителям парентеральных эшерихиозов не вырабатывается. Специфическая профилактика не разработана.
 Эпидемиологические особенности ЕТЕС – антропоноз; . Максимальна заболеваемость у детей после прекращения грудного вскармливания. Высокая инфицирующая доза. ЕРЕС – антропоноз. Максимальная заболеваемость у детей до 2 лет. В старшем возрасте высока частота бессимптомного носительства. EIEC – антропоноз. Эпидемиология сходна с шигеллезами, но инфицирующая доза выше. EHEC – зооноз; естественный резервуар – крупный рогатый скот, реже- свиньи, собаки, куры. Низкая инфицирующая доза. Пищевой, реже водный путь передачи. EAg. EC – антропоноз. В основном – спорадическая заболеваемость. У части пациентов в форме длительного (около 14 дней) энтерита без фебриллитета. DAEC- антропоноз? Эпидемиология изучена недостаточно
Эпидемиологические особенности ЕТЕС – антропоноз; . Максимальна заболеваемость у детей после прекращения грудного вскармливания. Высокая инфицирующая доза. ЕРЕС – антропоноз. Максимальная заболеваемость у детей до 2 лет. В старшем возрасте высока частота бессимптомного носительства. EIEC – антропоноз. Эпидемиология сходна с шигеллезами, но инфицирующая доза выше. EHEC – зооноз; естественный резервуар – крупный рогатый скот, реже- свиньи, собаки, куры. Низкая инфицирующая доза. Пищевой, реже водный путь передачи. EAg. EC – антропоноз. В основном – спорадическая заболеваемость. У части пациентов в форме длительного (около 14 дней) энтерита без фебриллитета. DAEC- антропоноз? Эпидемиология изучена недостаточно
 Лабораторная диагностика 1. Бактериологический метод 2. Серологический метод (ИФА для обнаружения LT- и ST -энтеротоксинов); 3. Молекулярно-генетический метод (ПЦР для обнаружение генов, кодирующих факторы вирулентности); 4. Иммунофлуоресцентный метод (прямой) как экспресс -метод во время вспышек кишечной инфекции
Лабораторная диагностика 1. Бактериологический метод 2. Серологический метод (ИФА для обнаружения LT- и ST -энтеротоксинов); 3. Молекулярно-генетический метод (ПЦР для обнаружение генов, кодирующих факторы вирулентности); 4. Иммунофлуоресцентный метод (прямой) как экспресс -метод во время вспышек кишечной инфекции
 Лабораторная диагностика q Ø Ø Ø Ø О-антигенная характеристика изолята E. coli в бактериологическом исследовании не во всех случаях четко коррелирует с наличием у него факторов вирулентности, определяющим принадлежность к одной из шести групп диарогенных эшерихий. Прямыми критериями отнесения E. coli к патогенетическим группам являются ключевые факторы вирулентности, наиболее охарактеризованные из которых представлены ниже. Для EHEC – продукция шигаподобных токсинов (веротоксинов) 1 и/или 2 типа, в сочетании с наличием интимина (eae-ген) или без него; Для ЕТЕС – продукция термостабильного (ST) или термолабильного (LT) токсинов, Для ЕРЕС – наличие так называемого А/Е (attaching and effacing) эффекта, обеспечиваемого интимином (eae – ген) при отсутствии генов шигаподобных токсинов, Для EIEC- наличие плазмидных генов факторов вирулентности (inv, ipa и др. ), Для EAg. EC – наличие плазмидных генов факторов вирулентности agg. R, asp. U, Для DAEC – afa – afimbrial factors adhesins, daa – DAEC F 1845 fimbriae и др.
Лабораторная диагностика q Ø Ø Ø Ø О-антигенная характеристика изолята E. coli в бактериологическом исследовании не во всех случаях четко коррелирует с наличием у него факторов вирулентности, определяющим принадлежность к одной из шести групп диарогенных эшерихий. Прямыми критериями отнесения E. coli к патогенетическим группам являются ключевые факторы вирулентности, наиболее охарактеризованные из которых представлены ниже. Для EHEC – продукция шигаподобных токсинов (веротоксинов) 1 и/или 2 типа, в сочетании с наличием интимина (eae-ген) или без него; Для ЕТЕС – продукция термостабильного (ST) или термолабильного (LT) токсинов, Для ЕРЕС – наличие так называемого А/Е (attaching and effacing) эффекта, обеспечиваемого интимином (eae – ген) при отсутствии генов шигаподобных токсинов, Для EIEC- наличие плазмидных генов факторов вирулентности (inv, ipa и др. ), Для EAg. EC – наличие плазмидных генов факторов вирулентности agg. R, asp. U, Для DAEC – afa – afimbrial factors adhesins, daa – DAEC F 1845 fimbriae и др.
 Лабораторная диагностика Клинический материал: испражнения. Рвотные массы и др. 1. Бактериологический метод 1 этап: Посев на среду Эндо с целью получения изолированных колоний. 2 этап: Изучение культуральных и морфологических свойств; постановка ориентировочной реакции агглютинации на стекле с поливалентной ОКА-коли сывороткой с материалом из лактозопозитивных колоний. Колонию с положительной реакцией отсевают на скошенный агар или среду Клиглера 3 этап: Идентификация по биохимическим свойствам (система API-20 E); серологическая (антигенная) идентификация с поливалентными OKB, OKC, OKD и OKE сыворотками, а затем последовательно с адсорбированными моновалентными ОК-сыворотками и групповой О-сывороткой с гретой культурой (при кипячении удаляется К-антиген)
Лабораторная диагностика Клинический материал: испражнения. Рвотные массы и др. 1. Бактериологический метод 1 этап: Посев на среду Эндо с целью получения изолированных колоний. 2 этап: Изучение культуральных и морфологических свойств; постановка ориентировочной реакции агглютинации на стекле с поливалентной ОКА-коли сывороткой с материалом из лактозопозитивных колоний. Колонию с положительной реакцией отсевают на скошенный агар или среду Клиглера 3 этап: Идентификация по биохимическим свойствам (система API-20 E); серологическая (антигенная) идентификация с поливалентными OKB, OKC, OKD и OKE сыворотками, а затем последовательно с адсорбированными моновалентными ОК-сыворотками и групповой О-сывороткой с гретой культурой (при кипячении удаляется К-антиген)
Агглютинация в РА на стекле с ОКАсывороткой означает принадлежность колонии к диареегенным эшерихиям Среда Клиглера до посева
Агглютинация в РА на стекле с ОКАсывороткой означает принадлежность колонии к диареегенным эшерихиям Среда Клиглера до посева
 Сыворотки диагностические эшерихиозные ОК поливалентные Действующим началом сывороток являются специфические К и О агглютинины против антигенов эшерихий патогенных ОК групп: О 44: К 74 О 114: К 90 О 127 а: К 63 ОКА: О 18 ас: К 77 О 20: К 84 О 119: К 69 О 75: К О 125: К 70 О 142: К 86 О 25: К 11 О 86 а: К 61 О 126: К 71 О 143: К О 26: К 60 О 111 аb: К 58 О 151: К О 144: К О 33: К ОКС: О 124: К 72 О 128 аdc: К 67 ОКВ: О 55: К 59 « 408» О 20: К 84 О 26: К 60 О 55: К 59 О 111 ab: К 58 О 128 abc: К 67 О 125: К 70 О 119: К 69 О 126: К 71 О 33: К О 127 а: К 63 ОКД: О 86 а: К 61 О 75: К О 143: К О 25: К 11 О 114: К 90 О 151: К О 44: К 74 ОКЕ: О 18 ас: К 77 О 142: К 86 « 408» О 124: К 72 О 142: К 86 О 143: К О 144: К О 151: К
Сыворотки диагностические эшерихиозные ОК поливалентные Действующим началом сывороток являются специфические К и О агглютинины против антигенов эшерихий патогенных ОК групп: О 44: К 74 О 114: К 90 О 127 а: К 63 ОКА: О 18 ас: К 77 О 20: К 84 О 119: К 69 О 75: К О 125: К 70 О 142: К 86 О 25: К 11 О 86 а: К 61 О 126: К 71 О 143: К О 26: К 60 О 111 аb: К 58 О 151: К О 144: К О 33: К ОКС: О 124: К 72 О 128 аdc: К 67 ОКВ: О 55: К 59 « 408» О 20: К 84 О 26: К 60 О 55: К 59 О 111 ab: К 58 О 128 abc: К 67 О 125: К 70 О 119: К 69 О 126: К 71 О 33: К О 127 а: К 63 ОКД: О 86 а: К 61 О 75: К О 143: К О 25: К 11 О 114: К 90 О 151: К О 44: К 74 ОКЕ: О 18 ас: К 77 О 142: К 86 « 408» О 124: К 72 О 142: К 86 О 143: К О 144: К О 151: К
 Серотипирование чистой культуры в реакции агглютинации на стекле ОКА-сыворотка Поливалентная Содержит Ат к 22 Аг серогрупп E. coli ОКВ «+» ОКЕ ОКД ОКС Поливалентные сыворотки более узкого спектра «+» «-» Моно-сыворотки ОК О 20: К 84 «-» О 26: К 60 «-» О 55: К 59 «-» О 111 ab: К 58 «+» РА групповой сыворотки с гретой культурой О 111 «+»
Серотипирование чистой культуры в реакции агглютинации на стекле ОКА-сыворотка Поливалентная Содержит Ат к 22 Аг серогрупп E. coli ОКВ «+» ОКЕ ОКД ОКС Поливалентные сыворотки более узкого спектра «+» «-» Моно-сыворотки ОК О 20: К 84 «-» О 26: К 60 «-» О 55: К 59 «-» О 111 ab: К 58 «+» РА групповой сыворотки с гретой культурой О 111 «+»
 Лечение v v v Антибиотики (амоксициллин и другие полусинтетические пенициллины; цефалоспорины, карбопенемы, аминогликозиды и др. Коли-фаг, коли-протейный бактериофаг, интести-фаг (содержит коли-бактериофаг) По окончании курса антибиотикотерапии рекомендованы препараты для коррекции микрофлоры кишечника: бифидумбактерин и др.
Лечение v v v Антибиотики (амоксициллин и другие полусинтетические пенициллины; цефалоспорины, карбопенемы, аминогликозиды и др. Коли-фаг, коли-протейный бактериофаг, интести-фаг (содержит коли-бактериофаг) По окончании курса антибиотикотерапии рекомендованы препараты для коррекции микрофлоры кишечника: бифидумбактерин и др.


